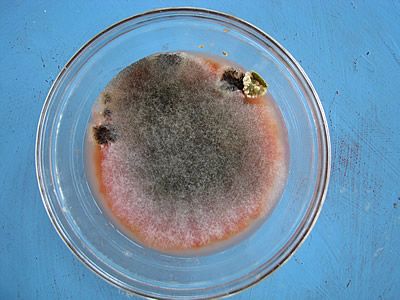
Στην επιφάνεια του μίγματος θα έχει αναπτυχθεί μούχλα

Σήμερα θα σας πω πως φτιάχνω σπόρους ντομάτας για την επόμενη χρονιά.
Καταρχάς, σημαδεύω από νωρίς τις ντομάτες που θα χρησιμοποιήσω για να πάρω σπόρους. Οι παλιοί λένε ότι οι πρώτοι καρποί είναι αυτοί που έχουν τα καλύτερα χαρακτηριστικά και από αυτούς πρέπει να συλλέγουμε σπόρους.
Δεν κόβω τις επιλεγμένες ντομάτες από τις ντοματιές, παρά μόνο όταν έχουν ωριμάσει αρκετά. Φροντίζω να μην επιλέγω μόνο τις πιο μεγάλες ή τις πιο καλοσχηματισμένες. Με αυτό τον τρόπο, θέλω να διατηρήσω μία ποικιλότητα.
Βήμα 1 – Αφαιρώ τους σπόρους τομάτας

Κόβω τις ντομάτες στη μέση και τις ζουλώ μέσα σε ένα μπολ ώστε να βγάλουν τα ζουμιά τους μαζί με τους σπόρους τους.
Βήμα 2 – Αραιώνω με νερό

Μέσα στο ζωμό ντομάτας, προσθέτω μισό ποτήρι νερό και ανακατεύω ώστε το μείγμα να ομογενοποιθεί. Το πόσο νερό θα βάλετε, εξαρτάται από τον όγκο του ζωμού ντομάτας.
Βήμα 3 – Σκεπάζω και αποθηκεύω το μίγμα
Σκεπάζω το μπολ με μία διαφανή μεμβράνη συσκευασίας, ώστε να μην έρχεται σε επαφή με το περιβάλλον.
Τοποθετώ το μπολ σε ένα σκιερό και δροσερό σημείο. Το αφήνω για 3 με 5 ημέρες.
Βήμα 4 – Ανάπτυξη μούχλας
Μετά από 3 με 5 ημέρες, η όψη του μείγματος θα είναι πολύ διαφορετική.
Στην επιφάνεια του μίγματος θα έχει αναπτυχθεί μούχλα. Μην τρομάζετε. Είναι μέρος της διαδικασίας. Είμαστε σε καλό δρόμο.
Βήμα 5 – Αφαιρώ τη μούχλα και ξεπλένω
Αφαιρώ την επιφανειακή μούχλα και αραιώνω το περιεχόμενο του μπωλ με μπόλικο φρέσκο νερό. Αδειάζω προσεκτικά, προσέχοντας να μη χάσω σπόρους. Επαναλαμβάνω όσες φορές χρειαστεί μέχρι οι σπόροι να καθαρίσουν.

Στη συνέχεια χρησιμοποιώ ένα σουρωτήρι για να απομακρύνω εντελώς το νερό και να κρατήσω μόνο τους σπόρους. Ξεπλένω ξανά και ξανά τους σπόρους ρίχνοντας νερό μέσα από το σουρωτήρι.
Βήμα 6 – Στεγνώνω
Απλώνω τους σπόρους σε ένα πιάτο (πλαστικό ή πορσελάνης) και τους βάζω να στεγνώσουν καλά σε ένα μέρος που είναι ζεστό και το βλέπει ο ήλιος για αρκετές ώρες.
Για να αποφύγετε οι σπόροι σας να γίνουν τροφή για τα πουλιά, μπορείτε να καλύψετε το πιάτο με ένα τούλι.
Αφήνω τους σπόρους για μερικές μέρες να στεγνώσουν εντελώς. Μία φορά την ημέρα τους ανακατεύω ώστε να αλλάξουν θέση.
Βήμα 7 – Αποθηκεύω
Αποθηκεύω τους σπόρους μέσα σε αεροστεγή βαζάκια. Καλά είναι αυτά που χρησιμοποιούν οι νοικοκυρές για να αποθηκεύουν γλυκά του κουταλιού. Μπορείτε να τα βρείτε σε σούπερ μάρκετ. Το μικρό μέγεθος που θέλουμε, κοστίζει λιγότερο από 2 Ευρώ.
Τοποθετώ το βάζο σε ένα σκοτεινό σημείο χωρίς πολύ υγρασία, μέχρι την επόμενη χρονιά που θα τους χρησιμοποιήσω.
Ελπίζω να βρήκατε χρήσιμη αυτή τη συμβουλή.
